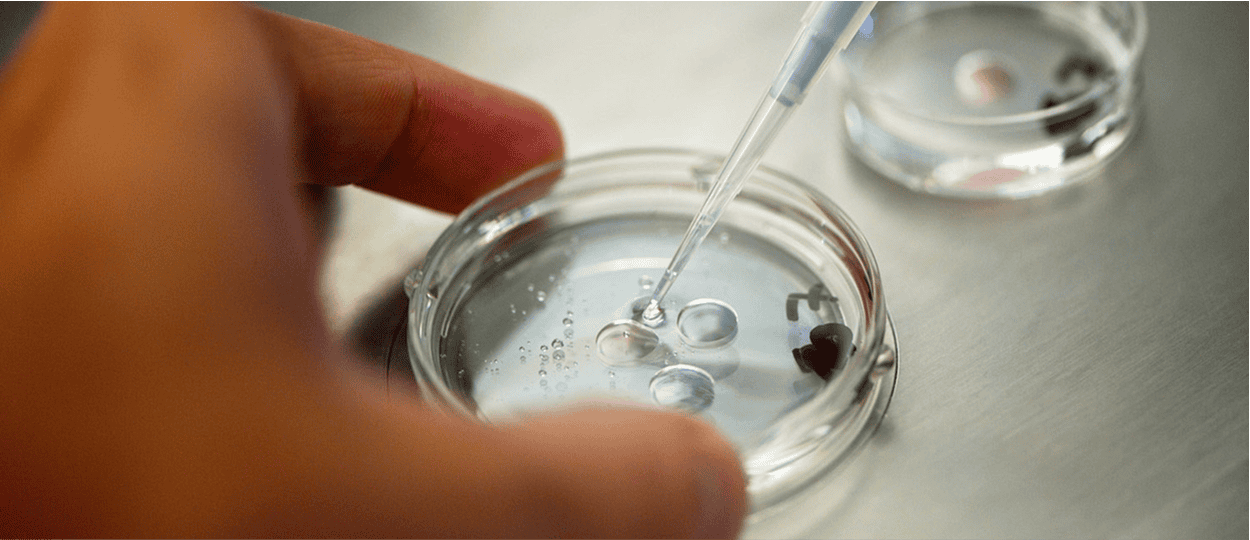

FIV – ICSI


Fécondation in vitro conventionnelle (FIVc) ou avec micro-injection de spermatozoïde (ICSI)
Qu’est-ce que la fécondation in vitro ?
La fécondation in vitro est le processus par lequel les ovocytes sont fécondés par un spermatozoïde à l’extérieur du corps, au laboratoire. Cela permet d’obtenir des embryons, dont le développement est observé pendant quelques jours. Par la suite, l’un des embryons est sélectionné pour être transféré dans l’utérus ou congelé pour une utilisation ultérieure.
Ainsi, la fécondation est parfois réalisée à partir d’ovocytes congelés, soit les vôtres, soit ceux d’une donneuse, selon votre situation.
Indications
La fécondation in vitro permet de surmonter les problèmes de fertilité du couple tels que :
Trompes de Fallope obstruées
Problèmes lié au facteur masculin
Problèmes lié au facteur ovarien
Tentatives d’insémination antérieures infructueuses
Infertilité d’origine inexpliquée

Procédure thérapeutique et biologique
La stimulation ovarienne
La FSH, ou hormone folliculo-stimulante, est l’hormone produite par l’hypophyse de la femme, qui agit sur les follicules en favorisant leur maturation. Les gonadotrophines sont des produits composés de FSH. L’objectif de la stimulation ovarienne en vue de FIV est d’obtenir la croissance de plusieurs follicules.
Cette procédure utilise l’injection quotidienne de gonadotrophines par voie sous-cutanée pendant environ 10 à 14 jours.
Avant le début des injections, vous pouvez avoir un prétraitement (comprimés d’œstrogènes ou une pilule œstroprogestative) pour harmoniser les résultats de la stimulation ovarienne.Le suivi
La stimulation ovarienne implique une surveillance rigoureuse et des ajustements précis pour maximiser les chances de succès tout en évitant les complications :
La croissance des follicules est surveillée par des contrôles réguliers, associant à la fois des échographies endovaginales et des prises de sang. Le bilan sanguin permet de mesurer les taux d’hormones dans le sang. Les échographies endovaginales ont pour but d’examiner les follicules, l’épaisseur et l’aspect de l’endomètre.
La date du premier contrôle vous sera donnée par votre médecin, généralement au 6e jour de traitement. À la suite de chaque contrôle, vous serez rappelée par les sages-femmes du centre dans l’après-midi afin de vous donner la conduite à tenir pour la suite, et si besoin la date du prochain contrôle.En fonction du protocole de stimulation que vous suivez, une seconde injection peut être administrée quotidiennement vers la fin de la stimulation pendant quelques jours, afin d’éviter une ovulation prématurée.
Lorsque la plupart des follicules atteignent un diamètre de 17 à 20 mm, une ou deux injections d’un traitement de déclenchement sont alors à effectuer, pour permettre la maturation finale des ovocytes et l’ovulation. L’heure de ces injections vous sera précisée par les sages-femmes. La ponction ovocytaire est alors programmée environ 36 heures plus tard et permet de recueillir le liquide folliculaire dans lequel baignent les ovocytes.En cas de réponse insuffisante, le médecin peut décider de ne pas aller jusqu’à la ponction ovocytaire.
La ponction ovocytaire
Il s’agit de la procédure par laquelle le liquide folliculaire est aspiré par voie transvaginale avec une aiguille, sous contrôle échographique. Cette procédure se réalise sous anesthésie locale, après une prémédication adaptée, et dure environ 20 minutes. Dans de rares cas, une anesthésie générale peut être indiquée.
Cette procédure présente un risque de sur-réponse, on parle d’hyperstimulation ovarienne. Dans la majorité des cas, les symptômes régressent spontanément après plusieurs jours. Si vous présentez des douleurs non soulagées par des antalgiques, des difficultés respiratoires, des troubles du transit ou urinaires, contactez-nous afin de savoir s’il est nécessaire de consulter. Dans les situations à risque de syndrome d’hyperstimulation, il est possible que vous n’ayez pas de transfert d’embryon frais, et qu’ils soient tous congelés en vue d’un transfert ultérieur.
Il existe aussi un risque hémorragique négligeable (< 1% des cas) qui pourrait nécessiter une surveillance prolongée en hospitalisation, voire une cœlioscopie exploratrice au bloc opératoire.
Une fois la ponction ovocytaire terminée, le liquide aspiré est examiné au microscope au laboratoire. Le nombre d’ovocytes collectés peut alors être connu.
Dans de rares cas, il arrive que la ponction ne retrouve aucun ovocyte. On parle alors de ponction blanche. Un bilan sanguin vous sera proposé afin de rechercher une cause potentielle.
Si vous êtes en couple, la présence de votre conjoint(e) le jour de la ponction est toujours nécessaire.
Dans le cas d’une FIV ou ICSI avec sperme du conjoint, celui-ci réalise son recueil de sperme le matin-même de la ponction dans notre laboratoire.Vous devez impérativement présenter un document officiel d’identité (carte d’identité, titre de séjour en cours de validité ou passeport) à chacune de vos venues. Les permis de conduire ne sont pas acceptés.
Après la ponction ovocytaire, vous resterez sur place pendant au moins 1h30, ou aussi longtemps que le personnel médical le jugera nécessaire. Dans tous les cas, vous devrez être accompagnée pour votre sortie de l’hôpital.
La douleur après la ponction ovocytaire est en général légère, puis s’estompe dans la journée. Elle ne nécessite généralement pas la prise d’antalgique. Un bulletin de situation faisant office d’arrêt de travail vous est fourni pour la journée. Il est important de se reposer.
Dès le lendemain, vous pourrez reprendre vos habitudes quotidiennes.
Des instructions médicales claires vous seront fournies concernant la suite du traitement, ainsi que des recommandations générales.Les spermatozoïdes
Recours à du sperme frais
La date exacte de votre recueil de sperme, en vue de FIV, vous sera confirmée par les sages-femmes 48h à l’avance.
Le recueil de sperme devra avoir lieu dans notre laboratoire.
Il est recommandé de respecter un délai d’abstinence sexuelle compris entre 2 et 7 jours avant votre prélèvement.Vous devez impérativement présenter un document officiel d’identité (carte d’identité, titre de séjour en cours de validité ou passeport) à chacune de vos venues. Les permis de conduire ne sont pas acceptés.
Vous serez placé en salle de recueil pour faire votre prélèvement. Au préalable, vous devrez compléter un document d’identification permettant la traçabilité de votre recueil. Sur ce document vous nous indiquerez si vous serez présent ou non le jour du transfert frais.
Recours à du sperme congelé
Sperme congelé du conjoint : la présence du conjoint est toujours obligatoire le jour de la tentative pour signer l’autorisation d’utilisation de ses spermatozoïdes.
Vous devez impérativement présenter un document officiel d’identité (carte d’identité, titre de séjour en cours de validité ou passeport) à chacune de vos venues. Les permis de conduire ne sont pas acceptés.
Sperme congelé du conjoint : la présence du conjoint est toujours obligatoire le jour de la tentative pour signer l’autorisation d’utilisation de ses spermatozoïdes.
Vous devez impérativement présenter un document officiel d’identité (carte d’identité, titre de séjour en cours de validité ou passeport) à chacune de vos venues. Les permis de conduire ne sont pas acceptés.
La fécondation
Le jour de la ponction, les ovocytes sont mis en présence de spermatozoïdes (du conjoint ou d’un donneur) en quantité suffisante pour permettre la fécondation. Si cela est jugé nécessaire, comme dans les cas d’une quantité ou mobilité insuffisantes des spermatozoïdes, une micro-injection d’un spermatozoïde dans chaque ovocyte (ICSI) est effectuée.
FIVc (fécondation in vitro classique) : Tous les ovocytes sont mis en contact avec une quantité précise de spermatozoïdes préalablement sélectionnés. La fécondation à proprement parler se fait de façon spontanée : un seul spermatozoïde fécondera l’ovocyte. Le lendemain matin, les ovocytes seront observés pour vérifier s’ils ont été fécondés.

ICSI (Intracytoplasmic Sperm Injection) : Les ovocytes sont dans un premier temps débarrassés de leurs cellules périphériques, ce qui nous permet d’identifier quels ovocytes peuvent être utilisés. Un spermatozoïde, sélectionné en fonction de sa mobilité et de sa morphologie, sera micro-injecté dans chaque ovocyte.
Ces deux techniques fonctionnent aussi bien l’une que l’autre, lorsqu’elles sont adaptées à votre situation. Toutefois, sachez qu’il est normal d’observer entre 60 et 80% d’ovocytes fécondés (le 100% étant rarement atteint). Dans des cas exceptionnels, il peut arriver qu’aucun ovocyte ne soit fécondé : il s’agit d’un échec de fécondation. La tentative est dès lors annulée, et votre dossier est rapidement discuté au sein de notre équipe pour pouvoir vous proposer une solution adaptée.
La culture embryonnaire
Notre laboratoire est équipé de la technologie Time-Lapse : les ovocytes fécondés sont placés dans une chambre d’incubation individuelle (une chambre d’incubation par couple ou par femme non mariée). Chaque chambre d’incubation est munie d’une caméra permettant de surveiller l’évolution des embryons sans perturber les conditions de culture.
Vos embryons pourront être laissés en culture jusqu’au 6e jour après la ponction en vue d’obtenir un développement au stade blastocyste, ces embryons donnant de meilleures chances de grossesse.
À partir de 48h après la ponction, puis chaque jour, nous vous informerons par téléphone du nombre et de la qualité des embryons en développement. Certains d’entre eux arrêtent leur développement en cours de culture : il est donc normal que le nombre d’embryons obtenus en fin de culture soit inférieur au nombre d’ovocytes fécondés au départ.
Seuls les embryons de bonne qualité seront aptes à être transférés ou congelés, selon les cas.
Le développement embryonnaire étant un processus complexe, il arrive parfois qu’aucun embryon ne soit utilisable, que ce soit en vue d’un transfert ou d’une congélation. Dans ce cas, la tentative est annulée, et votre dossier est rapidement discuté au sein de notre équipe pour pouvoir vous proposer une solution adaptée.

JOUR 0

JOUR 1

JOUR 2

JOUR 3

JOUR 4

JOUR 5

JOUR 6
Le transfert d’embryons
Parmi les embryons obtenus, un seul d’entre eux sera sélectionné pour être transféré dans l’utérus. De manière exceptionnelle, un transfert de 2 embryons peut être envisagé, sur proposition de l’équipe médicale.
Le transfert d’embryon a généralement lieu au stade du 5e jour (stade blastocyste) ou dans de rares cas, au 2e ou au 3e jour (stades précoces).
Il n’est pas toujours possible de réaliser le transfert d’embryon pour des raisons d’inadéquation hormonale, de syndrome d’hyperstimulation oude causes anatomiques (polype, fibrome par exemple). Dans ces cas, les embryons obtenus qui sont de bonne qualité seront congelés (cryoconservation).
Dans le cas où un transfert frais est possible, vous serez contacté(e) le matin-même (début de matinée) par un biologiste pour vous indiquer l’heure du rendez-vous (fin de matinée). Si vous êtes en couple, il est impératif que les deux membres du couple soient présents pour le transfert.
Vous devez impérativement présenter un document officiel d’identité (carte d’identité, titre de séjour en cours de validité ou passeport) à chacune de vos venues. Les permis de conduire ne sont pas acceptés.
La patiente est installée en position gynécologique. Après pose du spéculum et visualisation du col utérin, l’embryon à transférer est aspiré dans un fin cathéter flexible puis déposé dans la cavité utérine. Ce geste est généralement pratiqué sous contrôle échographique. Il s’agit d’une procédure indolore qui se fait sans anesthésie.

Une fois le transfert d’embryon terminé, des instructions médicales claires vous seront fournies concernant la suite du traitement, ainsi que des recommandations générales.
Après le transfert d’embryon, vous pourrez reprendre le cours normal de votre journée. Il n’existe pas de contre-indication à aller travailler.La prise de sang pour détecter l’hCG (ou hormone chorionique gonadotrope) est à réaliser à une date qui vous sera précisée.
La cryoconservation des embryons
La cryoconservation (congélation) concerne les embryons de bonne qualité qui n’ont pas fait l’objet d’un transfert. Ils seront cryoconservés pour une utilisation future.
Dans le cas où vous n’auriez pas utilisé vos embryons dans l’année qui suit leur congélation, un courrier vous sera adressé annuellement pour connaître votre décision concernant leur devenir.Le développement embryonnaire étant un processus complexe, il arrive parfois qu’aucun embryon ne soit apte à être congelé.
Sperme congelé du conjoint : la présence du conjoint est toujours obligatoire le jour de la tentative pour signer l’autorisation d’utilisation de ses spermatozoïdes.
Vous devez impérativement présenter un document officiel d’identité (carte d’identité, titre de séjour en cours de validité ou passeport) à chacune de vos venues. Les permis de conduire ne sont pas acceptés.
Sperme congelé du conjoint : la présence du conjoint est toujours obligatoire le jour de la tentative pour signer l’autorisation d’utilisation de ses spermatozoïdes.
Vous devez impérativement présenter un document officiel d’identité (carte d’identité, titre de séjour en cours de validité ou passeport) à chacune de vos venues. Les permis de conduire ne sont pas acceptés.

JOUR 0

JOUR 1

JOUR 2

JOUR 3

JOUR 4

JOUR 5

JOUR 6
La stimulation ovarienne
La FSH, ou hormone folliculo-stimulante, est l’hormone produite par l’hypophyse de la femme, qui agit sur les follicules en favorisant leur maturation. Les gonadotrophines sont des produits composés de FSH. L’objectif de la stimulation ovarienne en vue de FIV est d’obtenir la croissance de plusieurs follicules.
Cette procédure utilise l’injection quotidienne de gonadotrophines par voie sous-cutanée pendant environ 10 à 14 jours.
Avant le début des injections, vous pouvez avoir un prétraitement (comprimés d’œstrogènes ou une pilule œstroprogestative) pour harmoniser les résultats de la stimulation ovarienne.
Le suivi
La stimulation ovarienne implique une surveillance rigoureuse et des ajustements précis pour maximiser les chances de succès tout en évitant les complications :
La croissance des follicules est surveillée par des contrôles réguliers, associant à la fois des échographies endovaginales et des prises de sang. Le bilan sanguin permet de mesurer les taux d’hormones dans le sang. Les échographies endovaginales ont pour but d’examiner les follicules, l’épaisseur et l’aspect de l’endomètre.
La date du premier contrôle vous sera donnée par votre médecin, généralement au 6e jour de traitement. À la suite de chaque contrôle, vous serez rappelée par les sages-femmes du centre dans l’après-midi afin de vous donner la conduite à tenir pour la suite, et si besoin la date du prochain contrôle.
En fonction du protocole de stimulation que vous suivez, une seconde injection peut être administrée quotidiennement vers la fin de la stimulation pendant quelques jours, afin d’éviter une ovulation prématurée.
Lorsque la plupart des follicules atteignent un diamètre de 17 à 20 mm, une ou deux injections d’un traitement de déclenchement sont alors à effectuer, pour permettre la maturation finale des ovocytes et l’ovulation. L’heure de ces injections vous sera précisée par les sages-femmes. La ponction ovocytaire est alors programmée environ 36 heures plus tard et permet de recueillir le liquide folliculaire dans lequel baignent les ovocytes.
En cas de réponse insuffisante, le médecin peut décider de ne pas aller jusqu’à la ponction ovocytaire.
La ponction ovocytaire
Il s’agit de la procédure par laquelle le liquide folliculaire est aspiré par voie transvaginale avec une aiguille, sous contrôle échographique. Cette procédure se réalise sous anesthésie locale, après une prémédication adaptée, et dure environ 20 minutes. Dans de rares cas, une anesthésie générale peut être indiquée.
Cette procédure présente un risque de sur-réponse, on parle d’hyperstimulation ovarienne. Dans la majorité des cas, les symptômes régressent spontanément après plusieurs jours. Si vous présentez des douleurs non soulagées par des antalgiques, des difficultés respiratoires, des troubles du transit ou urinaires, contactez-nous afin de savoir s’il est nécessaire de consulter. Dans les situations à risque de syndrome d’hyperstimulation, il est possible que vous n’ayez pas de transfert d’embryon frais, et qu’ils soient tous congelés en vue d’un transfert ultérieur.
Il existe aussi un risque hémorragique négligeable (< 1% des cas) qui pourrait nécessiter une surveillance prolongée en hospitalisation, voire une cœlioscopie exploratrice au bloc opératoire.

Une fois la ponction ovocytaire terminée, le liquide aspiré est examiné au microscope au laboratoire. Le nombre d’ovocytes collectés peut alors être connu.
Dans de rares cas, il arrive que la ponction ne retrouve aucun ovocyte. On parle alors de ponction blanche. Un bilan sanguin vous sera proposé afin de rechercher une cause potentielle.
Si vous êtes en couple, la présence de votre conjoint(e) le jour de la ponction est toujours nécessaire.
Dans le cas d’une FIV ou ICSI avec sperme du conjoint, celui-ci réalise son recueil de sperme le matin-même de la ponction dans notre laboratoire.
Vous devez impérativement présenter un document officiel d’identité (carte d’identité, titre de séjour en cours de validité ou passeport) à chacune de vos venues. Les permis de conduire ne sont pas acceptés.
Après la ponction ovocytaire, vous resterez sur place pendant au moins 1h30, ou aussi longtemps que le personnel médical le jugera nécessaire. Dans tous les cas, vous devrez être accompagnée pour votre sortie de l’hôpital.
La douleur après la ponction ovocytaire est en général légère, puis s’estompe dans la journée. Elle ne nécessite généralement pas la prise d’antalgique. Un bulletin de situation faisant office d’arrêt de travail vous est fourni pour la journée. Il est important de se reposer.
Dès le lendemain, vous pourrez reprendre vos habitudes quotidiennes.
Des instructions médicales claires vous seront fournies concernant la suite du traitement, ainsi que des recommandations générales.
Les spermatozoïdes
Recours à du sperme frais
La date exacte de votre recueil de sperme, en vue de FIV, vous sera confirmée par les sages-femmes 48h à l’avance.
Le recueil de sperme devra avoir lieu dans notre laboratoire.
Il est recommandé de respecter un délai d’abstinence sexuelle compris entre 2 et 7 jours avant votre prélèvement.
Vous devez impérativement présenter un document officiel d’identité (carte d’identité, titre de séjour en cours de validité ou passeport) à chacune de vos venues. Les permis de conduire ne sont pas acceptés.
Vous serez placé en salle de recueil pour faire votre prélèvement. Au préalable, vous devrez compléter un document d’identification permettant la traçabilité de votre recueil. Sur ce document vous nous indiquerez si vous serez présent ou non le jour du transfert frais.
Recours à du sperme congelé
La fécondation
Le jour de la ponction, les ovocytes sont mis en présence de spermatozoïdes (du conjoint ou d’un donneur) en quantité suffisante pour permettre la fécondation. Si cela est jugé nécessaire, comme dans les cas d’une quantité ou mobilité insuffisantes des spermatozoïdes, une micro-injection d’un spermatozoïde dans chaque ovocyte (ICSI) est effectuée.
FIVc (fécondation in vitro classique) : Tous les ovocytes sont mis en contact avec une quantité précise de spermatozoïdes préalablement sélectionnés. La fécondation à proprement parler se fait de façon spontanée : un seul spermatozoïde fécondera l’ovocyte. Le lendemain matin, les ovocytes seront observés pour vérifier s’ils ont été fécondés.

ICSI (Intracytoplasmic Sperm Injection) : Les ovocytes sont dans un premier temps débarrassés de leurs cellules périphériques, ce qui nous permet d’identifier quels ovocytes peuvent être utilisés. Un spermatozoïde, sélectionné en fonction de sa mobilité et de sa morphologie, sera micro-injecté dans chaque ovocyte.
Ces deux techniques fonctionnent aussi bien l’une que l’autre, lorsqu’elles sont adaptées à votre situation. Toutefois, sachez qu’il est normal d’observer entre 60 et 80% d’ovocytes fécondés (le 100% étant rarement atteint). Dans des cas exceptionnels, il peut arriver qu’aucun ovocyte ne soit fécondé : il s’agit d’un échec de fécondation. La tentative est dès lors annulée, et votre dossier est rapidement discuté au sein de notre équipe pour pouvoir vous proposer une solution adaptée.
La culture embryonnaire
Notre laboratoire est équipé de la technologie Time-Lapse : les ovocytes fécondés sont placés dans une chambre d’incubation individuelle (une chambre d’incubation par couple ou par femme non mariée). Chaque chambre d’incubation est munie d’une caméra permettant de surveiller l’évolution des embryons sans perturber les conditions de culture.
Vos embryons pourront être laissés en culture jusqu’au 6e jour après la ponction en vue d’obtenir un développement au stade blastocyste, ces embryons donnant de meilleures chances de grossesse.
À partir de 48h après la ponction, puis chaque jour, nous vous informerons par téléphone du nombre et de la qualité des embryons en développement. Certains d’entre eux arrêtent leur développement en cours de culture : il est donc normal que le nombre d’embryons obtenus en fin de culture soit inférieur au nombre d’ovocytes fécondés au départ.
Seuls les embryons de bonne qualité seront aptes à être transférés ou congelés, selon les cas.
Le développement embryonnaire étant un processus complexe, il arrive parfois qu’aucun embryon ne soit utilisable, que ce soit en vue d’un transfert ou d’une congélation. Dans ce cas, la tentative est annulée, et votre dossier est rapidement discuté au sein de notre équipe pour pouvoir vous proposer une solution adaptée.
Le transfert d’embryons
Parmi les embryons obtenus, un seul d’entre eux sera sélectionné pour être transféré dans l’utérus. De manière exceptionnelle, un transfert de 2 embryons peut être envisagé, sur proposition de l’équipe médicale.
Le transfert d’embryon a généralement lieu au stade du 5e jour (stade blastocyste) ou dans de rares cas, au 2e ou au 3e jour (stades précoces).
Il n’est pas toujours possible de réaliser le transfert d’embryon pour des raisons d’inadéquation hormonale, de syndrome d’hyperstimulation oude causes anatomiques (polype, fibrome par exemple). Dans ces cas, les embryons obtenus qui sont de bonne qualité seront congelés (cryoconservation).
Dans le cas où un transfert frais est possible, vous serez contacté(e) le matin-même (début de matinée) par un biologiste pour vous indiquer l’heure du rendez-vous (fin de matinée). Si vous êtes en couple, il est impératif que les deux membres du couple soient présents pour le transfert.
Vous devez impérativement présenter un document officiel d’identité (carte d’identité, titre de séjour en cours de validité ou passeport) à chacune de vos venues. Les permis de conduire ne sont pas acceptés.
La patiente est installée en position gynécologique. Après pose du spéculum et visualisation du col utérin, l’embryon à transférer est aspiré dans un fin cathéter flexible puis déposé dans la cavité utérine. Ce geste est généralement pratiqué sous contrôle échographique. Il s’agit d’une procédure indolore qui se fait sans anesthésie.
Une fois le transfert d’embryon terminé, des instructions médicales claires vous seront fournies concernant la suite du traitement, ainsi que des recommandations générales.
Après le transfert d’embryon, vous pourrez reprendre le cours normal de votre journée. Il n’existe pas de contre-indication à aller travailler.
La prise de sang pour détecter l’hCG (ou hormone chorionique gonadotrope) est à réaliser à une date qui vous sera précisée.
La cryoconservation des embryons
La cryoconservation (congélation) concerne les embryons de bonne qualité qui n’ont pas fait l’objet d’un transfert. Ils seront cryoconservés pour une utilisation future.
Dans le cas où vous n’auriez pas utilisé vos embryons dans l’année qui suit leur congélation, un courrier vous sera adressé annuellement pour connaître votre décision concernant leur devenir.
Le développement embryonnaire étant un processus complexe, il arrive parfois qu’aucun embryon ne soit apte à être congelé.
